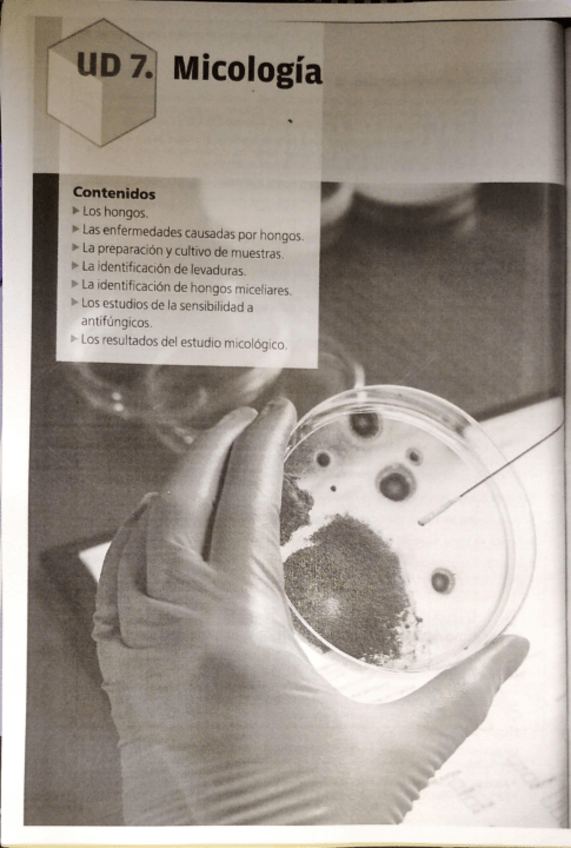
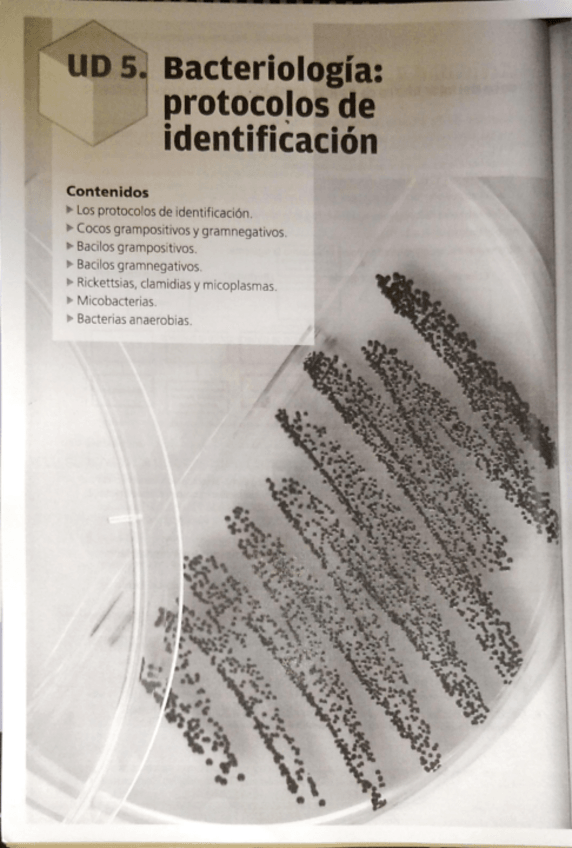
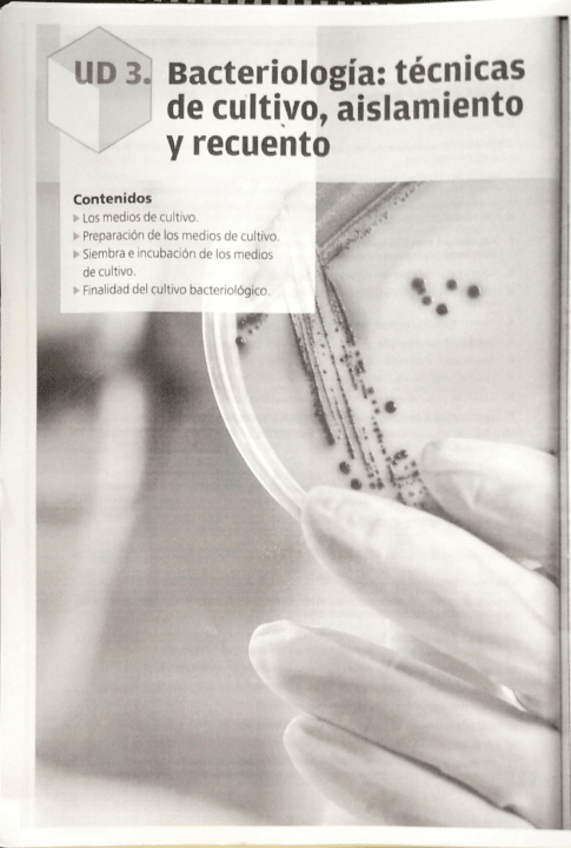
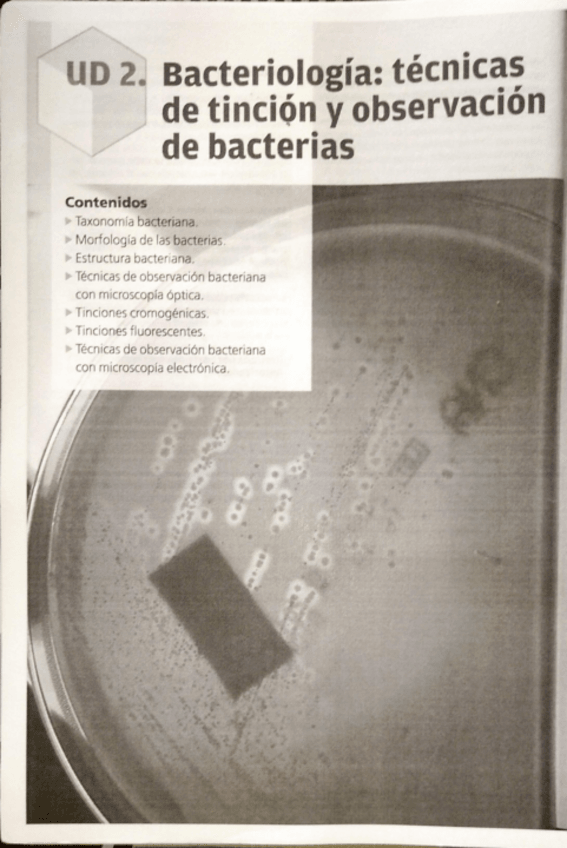
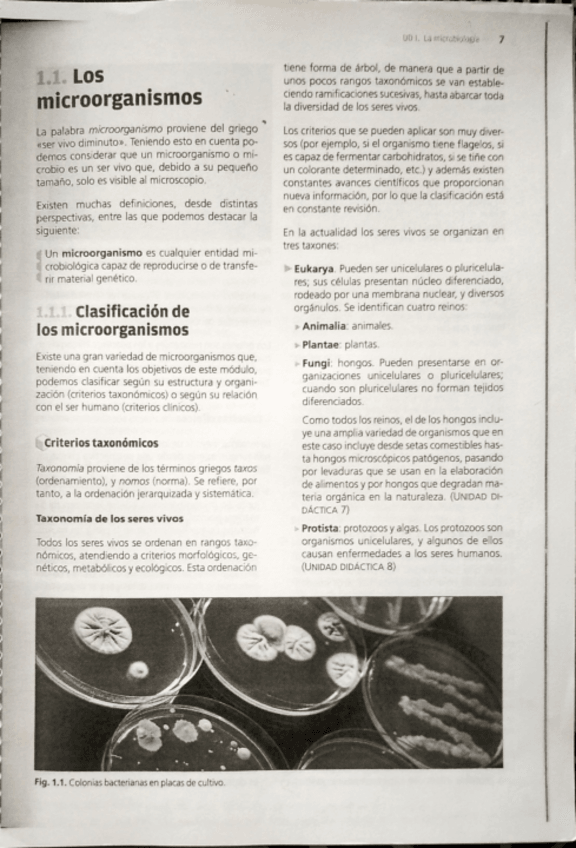
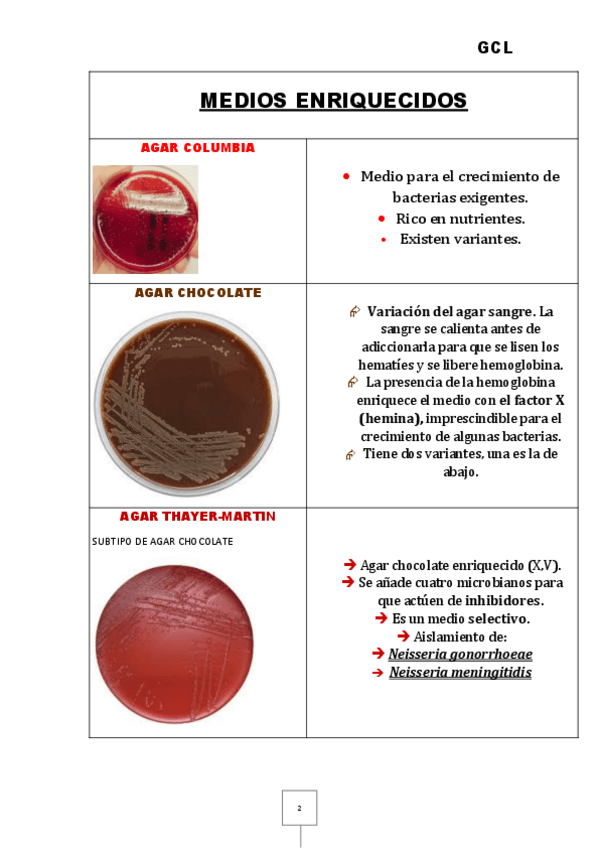

CENTRO INTEGRADO DE FORMACIÓN PROFESIONAL DE LORCA - Laboratorio Clínico y Biomédico
Murcia
Sube tus apuntes
arrow_forwardAsignaturas de CENTRO INTEGRADO DE FORMACIÓN PROFESIONAL DE LORCA - Laboratorio Clínico y Biomédico
Asignatura
arrow_downwardÚltimas publicaciones de CENTRO INTEGRADO DE FORMACIÓN PROFESIONAL DE LORCA - Laboratorio Clínico y Biomédico
He publicado nuevos apuntes de Fisiopatología general: UD-6-FISIOPATOLOGIA-URINARIA-2.pdf
He publicado nuevos apuntes de Análisis bioquímico: Tema-1-Tecnicas-de-laboratorio-de-bioquimica-clinica-I.pdf
He publicado nuevos apuntes de Análisis bioquímico: Tema-9-Estudios-bioquimicos-especiales-.pdf
He publicado nuevos apuntes de Análisis bioquímico: Tema-8-Estudio-bioquimico-de-otras-muestras-biologicas-.pdf
He publicado nuevos apuntes de Análisis bioquímico: Tema-7-Tecnicas-de-estudio-en-muestras-de-orina.pdf
He publicado nuevos apuntes de Análisis bioquímico: Tema-6-Determinacion-de-enzimas-.pdf
He publicado nuevos apuntes de Análisis bioquímico: Tema-5-Magnitudes-equilibrios-hidroelectrolitico-y-acido-base.pdf
He publicado nuevos apuntes de Análisis bioquímico: Tema-4-Magnitudes-productos-finales-del-metabolismo-.pdf
He publicado nuevos apuntes de Análisis bioquímico: Tema-3-Magnitudes-metabolismo-de-principios-inmediatos-.pdf
He publicado nuevos apuntes de Análisis bioquímico: Tema-2-Tecnicas-del-laboratorio-de-bioquimica-clinica-II.pdf
He publicado nuevos apuntes de Microbiología clínica: TEMA-4-BACTERIOLOGIA-TECNICAS-DE-IDENTIFICACION-Y-ANTIBIOGRAMAS-2.pdf
He publicado nuevos apuntes de Análisis bioquímico: TEMA-1-TECNICAS-DEL-LABORATORIO-DE-BIOQUIMICA-CLINICA-I.pdf
He publicado nuevos apuntes de Técnicas de inmunodiagnóstico: Tema-3-aplicacion-de-tecnicas-basadas-en-reacciones-antigeno-anticuerpo-primarias-.pdf
He publicado nuevos apuntes de Técnicas de inmunodiagnóstico: Tema-2-Aplicaciones-de-tecnicas-basadas-en-reacciones-antigeno-anticuerpo-secundarias-.pdf
He publicado nuevos apuntes de Técnicas de inmunodiagnóstico: Tema-1-el-sistema-inmunitario-.pdf
He publicado nuevos apuntes de Microbiología clínica: Tema-9-virologia-.pdf
He publicado nuevos apuntes de Microbiología clínica: Tema-8-parasitologia-.pdf
He publicado nuevos apuntes de Microbiología clínica: Tema-7-Micologia-.pdf
He publicado nuevos apuntes de Microbiología clínica: Tema-6-bacteriologia-estudio-de-muestras-biologicas-.pdf
He publicado nuevos apuntes de Microbiología clínica: Tema-5-bacteriologia-protocolos-de-identificacion-.pdf
He publicado nuevos apuntes de Microbiología clínica: Tema-4-bacteriologia-tecnicas-de-identificacion-y-antibiogramas.pdf
He publicado nuevos apuntes de Microbiología clínica: Tema-3-Bacteriologia-tecnicas-de-cultivo-aislamiento-y-recuento-.pdf
He publicado nuevos apuntes de Microbiología clínica: Tema-2-Bacteriologia-tecnicas-de-tincion-y-observacion-de-bacterias-.pdf
He publicado nuevos apuntes de Microbiología clínica: Tema-1-La-microbiologia-.pdf
He publicado nuevos apuntes de Técnicas generales de laboratorio: Ejercicios-Tema-8.pdf
He publicado nuevos apuntes de Técnicas generales de laboratorio: 20220308-2121-Office-Lens.pdf
He publicado nuevos apuntes de Técnicas generales de laboratorio: 20220308-2119-Office-Lens.pdf
He publicado nuevos apuntes de Técnicas generales de laboratorio: 20220203-829-Office-Lens.pdf
He publicado nuevos apuntes de Técnicas generales de laboratorio: 20211210-1022-Office-Lens.pdf
He publicado nuevos apuntes de Técnicas generales de laboratorio: tema-9-tecnicas.pdf
He publicado nuevos apuntes de Fisiopatología general: INFECCIONES-Y-NEOPLASIAS.pdf
He publicado nuevos ejercicios de Técnicas generales de laboratorio: actividades-3-tgl.pdf
He publicado nuevos ejercicios de Técnicas generales de laboratorio: ACTIVIDADES-UD-2-TGL.pdf
He publicado nuevos ejercicios de Técnicas generales de laboratorio: ACTIVIDADES-UT1-TGL.pdf
He publicado nuevos apuntes de Análisis bioquímico: tema-5-bioquimica.pdf
He publicado nuevos apuntes de Análisis bioquímico: cuadro-Electrolitos-de-interes-diagnostico.pdf
He publicado nuevos apuntes de Análisis bioquímico: Ejercicios-Tema-5-bioquimica.pdf
apuntes
-
tema 3 y 4 bioquimica
He publicado nuevos apuntes de Análisis bioquímico: tema 3 y 4 bioquimica
He publicado nuevos apuntes de Análisis bioquímico: tema-1-TECNICAS-DE-LABORATORIO-BIOQUIMICA-CLINICA-1.pdf
He publicado nuevos apuntes de Análisis bioquímico: ejercicios-tema-2-bioquimica.docx
He publicado nuevos apuntes de Microbiología clínica: TIPOS-DE-MEDIOS-GCL.pdf
He publicado nuevos apuntes de Microbiología clínica: RESUMEN-UNIDAD-9.pdf